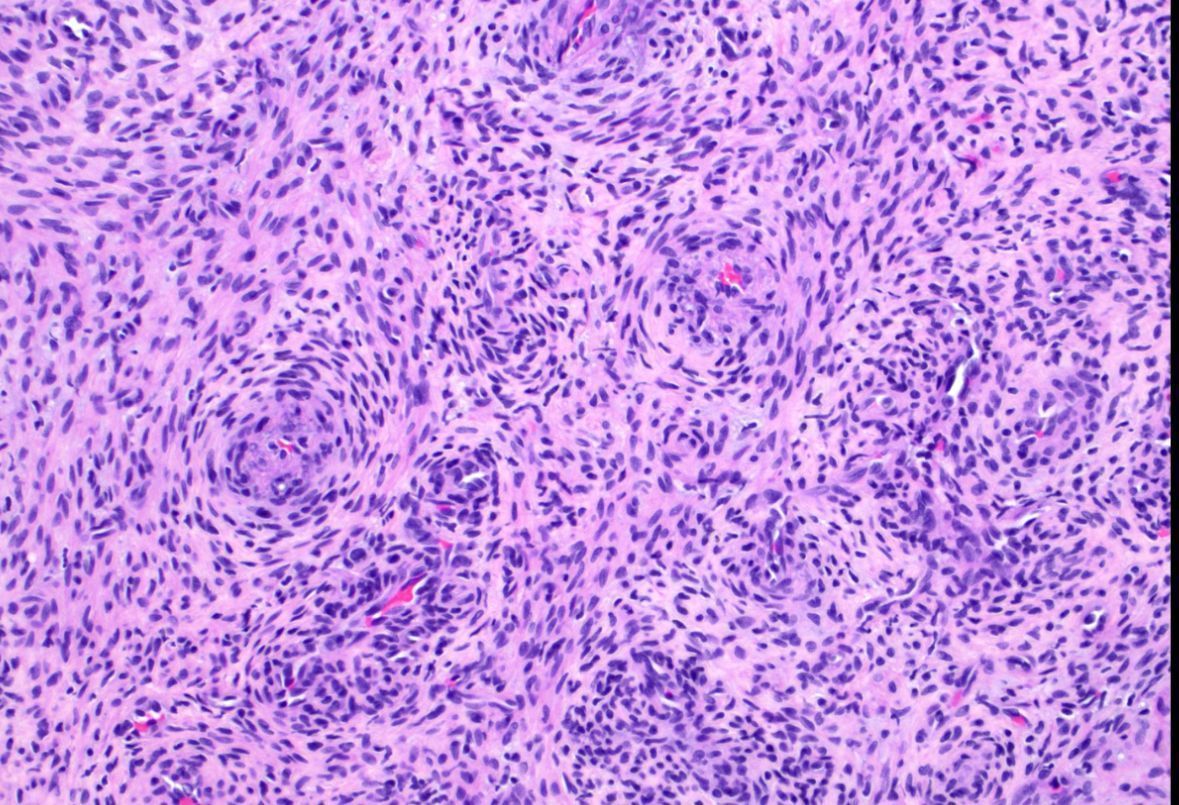

What process is happening here? How old is this patient?
Answers & pics w labels: kikoxp.com/posts/20899
Video explanation: youtu.be/90sx3yrw4t4?si…
#BSTpath #pathologists #pathology #pathTwitter #histology #orthotwitter #pedstwitter #medtwitter
2
183